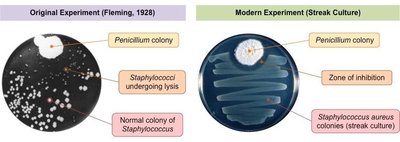
Fleming's original experiment and modern streak culture showing penicillin's zone of inhibition

BackAntimicrobial Drugs: Principles, Mechanisms, and Resistance
Study Guide - Smart Notes
Tailored notes based on your materials, expanded with key definitions, examples, and context.
Antimicrobial Drugs: Introduction and Historical Context
Definition and Importance
Antimicrobial drugs are therapeutic compounds designed to kill or inhibit the growth of microbes, thereby preventing or treating infectious diseases. Their development has revolutionized modern medicine, drastically reducing mortality from infections that were once often fatal.
Antimicrobial drug: Any substance that kills or inhibits the growth of microorganisms, including bacteria, viruses, fungi, and parasites.
Antibiotic: A type of antimicrobial specifically targeting bacteria.
Antimicrobials are categorized by the type of pathogen they target: antibacterials, antivirals, antifungals, and antiparasitic agents.

Discovery of Penicillin
The discovery of penicillin marked the beginning of the antibiotic era. In 1928, Alexander Fleming observed that a mold, later identified as Penicillium, inhibited the growth of Staphylococcus aureus on a culture plate. This led to the isolation and mass production of penicillin, the first clinically used antibiotic.
Zone of inhibition: The clear area around the mold where bacterial growth was prevented, indicating antimicrobial activity.
Spectrum of Activity and Empiric Therapy
Spectrum of Activity
The spectrum of activity refers to the range of microbes an antimicrobial drug can affect.
Broad-spectrum: Effective against a wide variety of microbes (e.g., both Gram-positive and Gram-negative bacteria).
Narrow-spectrum: Targets a limited group of microbes, minimizing disruption to normal microbiota but requiring precise pathogen identification.
Limited-spectrum: Effective against a single organism or disease.
Empiric Therapy
Empiric therapy involves starting treatment with a broad-spectrum drug based on clinical judgment before the specific pathogen is identified. Once laboratory results are available, therapy should be adjusted to a narrow-spectrum agent to minimize side effects and resistance development.

Classification and Modification of Antimicrobial Drugs
Sources of Antimicrobial Drugs
Naturally occurring: Produced by microorganisms (e.g., soil bacteria and fungi).
Synthetic: Fully manufactured by chemical processes.
Semisynthetic: Chemically modified derivatives of natural antibiotics to improve efficacy, spectrum, or pharmacokinetics.

Drug Modification and Generations
Chemical modification of antibiotics (e.g., adding R groups) leads to new generations with improved properties such as broader spectrum, increased stability, and reduced toxicity.
Example: Ampicillin and amoxicillin are semisynthetic derivatives of penicillin G, with broader activity due to enhanced ability to penetrate Gram-negative cell walls.

Principles of Antimicrobial Drug Action
Selective Toxicity and Therapeutic Index
Antimicrobial drugs must exhibit selective toxicity, targeting microbial structures or functions not present in the host. The therapeutic index (TI) is the ratio of the toxic dose to the therapeutic dose, indicating the drug's safety margin.
High TI: Wide margin of safety; less risk of toxicity.
Low TI: Narrow margin; higher risk of adverse effects.

Toxicity Considerations
Antimicrobials can cause toxicity to key organs involved in drug metabolism and elimination, especially the liver (hepatotoxicity) and kidneys (nephrotoxicity), as well as disrupt the gut microbiome.
Hepatotoxicity: Drug-induced liver injury.
Nephrotoxicity: Drug-induced kidney damage.
Gut microbiome toxicity: Disruption of normal intestinal flora.

Routes of Administration
Oral: Preferred for convenience and cost; requires stability in the stomach and absorption in the intestines.
Parenteral: Non-oral routes (e.g., intravenous, intramuscular, subcutaneous, intradermal) allow rapid drug delivery but require injections.

Drug Half-Life and Interactions
Half-life: Time required for half the drug to be eliminated from the body; determines dosing frequency.
Drug interactions: Some antimicrobials interact with other drugs, foods, or supplements, affecting efficacy or causing adverse effects.

Mechanisms and Targets of Antimicrobial Drugs
Antibacterial Drug Mechanisms
Antibacterial drugs exploit differences between prokaryotic and eukaryotic cells, targeting bacterial-specific structures and processes.
Cell wall synthesis inhibitors (e.g., penicillins, cephalosporins)
Protein synthesis inhibitors (e.g., tetracyclines, macrolides)
Nucleic acid synthesis inhibitors (e.g., quinolones, rifamycins)
Cell membrane disruptors (e.g., polymyxins)
Metabolic pathway inhibitors (e.g., sulfa drugs, trimethoprim)

Bacteriostatic vs. Bactericidal Drugs
Bacteriostatic: Inhibit bacterial growth; rely on the host immune system for pathogen clearance.
Bactericidal: Kill bacteria directly; useful in immunocompromised patients or severe infections.
CATEGORY | BACTERICIDAL | BACTERIOSTATIC |
|---|---|---|
Definition | Substance that kills bacteria | Substance that inhibits bacterial growth |
Minimum Concentration | MBC (minimum bactericidal concentration) | MIC (minimum inhibitory concentration) |
Number of Bacterial Cells | Number decreases | Number remains the same |
Viability of Bacteria | Bacteria die | Bacteria remain viable |
Activation of Immune System | No effect | Helps immune system |
High Dose Effect | Kills all bacterial cells | May act as bactericidal at high doses |
Low Dose Effect | May act as bacteriostatic | May not be effective |
Reversibility | Irreversible | Reversible |
Antiviral, Antifungal, and Antiparasitic Drugs
Antivirals: Target steps in viral replication (attachment, penetration, uncoating, replication, assembly, release) or stimulate host immune responses. Most effective against actively replicating viruses.
Antifungals: Target fungal-specific structures such as ergosterol in cell membranes, cell wall synthesis, or nucleic acid synthesis.
Antiparasitics: Target unique features of protozoa or helminths, but development is challenging due to similarities with host cells and complex life cycles.

Assessing Sensitivity to Antimicrobial Drugs
Antibiotic Susceptibility Testing (AST)
AST determines which antimicrobials are effective against a specific pathogen. Common methods include:
Kirby-Bauer disk diffusion: Measures zone of inhibition to determine susceptibility.
E-test: Uses a drug gradient strip to determine minimum inhibitory concentration (MIC).
Broth dilution: Determines MIC and minimum bactericidal concentration (MBC) by serially diluting drugs in broth and assessing bacterial growth and viability.
Antimicrobial Drug Resistance and Stewardship
Types of Resistance
Intrinsic resistance: Natural, due to inherent structural or functional characteristics (e.g., lack of cell wall, biofilm formation, impermeable outer membrane).
Acquired resistance: Due to genetic mutations or acquisition of resistance genes via horizontal gene transfer (conjugation, transformation, transduction).
Mechanisms of Acquired Resistance
Alteration of drug target (e.g., mutation in binding site)
Inactivation of drug (e.g., enzymatic degradation or modification)
Reduced drug concentration (e.g., decreased permeability, efflux pumps)
Superbugs and Superinfections
Superbugs: Microbes resistant to multiple antimicrobials.
Superinfection: Secondary infection by resistant organisms after normal microbiota are eliminated by broad-spectrum antibiotics.

Factors Accelerating Resistance
Noncompliance with prescribed regimens
Misuse and overuse of antimicrobials in healthcare and agriculture
Unregulated antibiotic use in some regions
Antimicrobial Stewardship
Stewardship programs promote the appropriate use of antimicrobials to improve patient outcomes, reduce resistance, and decrease the spread of multidrug-resistant organisms. Key strategies include:
Limiting unnecessary prescriptions
Using narrow-spectrum drugs when possible
Educating patients and healthcare workers
Proper hand hygiene and infection control
Summary Table: Types of Antimicrobial Therapy
Type of Therapy | Description |
|---|---|
Prophylaxis | Antibiotics used to prevent infection |
Empiric | Organism is unknown but syndrome is known |
Pathogen-directed | Organism is known but susceptibility is unknown |
Susceptibility-guided | Organism is known and susceptibility is known |
Additional info: This guide covers foundational concepts in antimicrobial drugs, including their discovery, classification, mechanisms of action, toxicity, resistance, and stewardship. Understanding these principles is essential for effective clinical practice and combating the global threat of antimicrobial resistance.